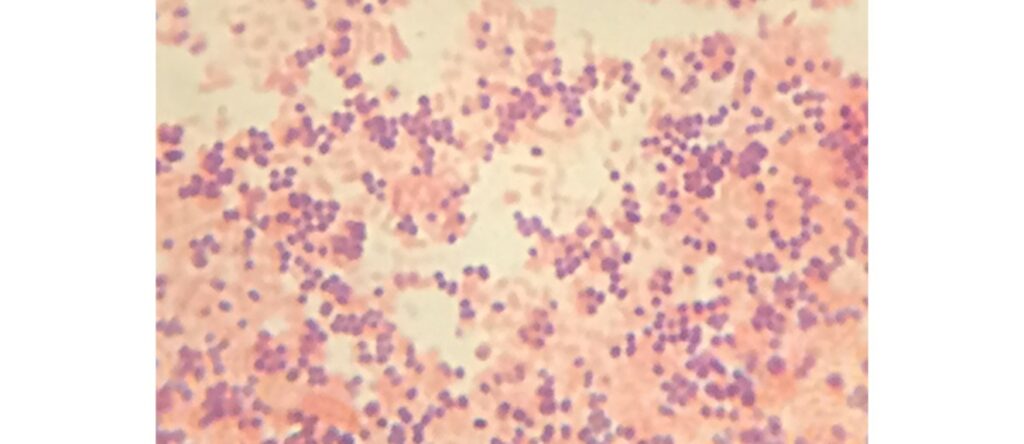
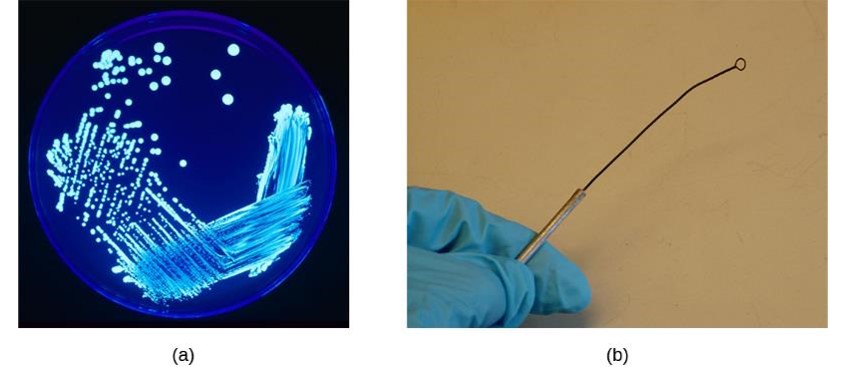

7
Zoë Soon
Learning Objectives
By the end of this section, you will be able to:
- Briefly describe endotoxin and exotoxin, Gram negative and LPS.
- Briefly describe culture and sensitivity testing.
Pathogens and the Immune System
Before contemplating the body’s immune system defenses, it can be helpful to discuss the characteristics of each pathogen type and explore what types of strategies they use to cause infection, as well as what types of immune system defense strategies are in place.
Bacteria Characteristics
In this section we will discuss bacteria characteristics. Besides being prokaryotic (anuclear) and unicellular, bacteria are the second smallest microorganism (viruses are the smallest) ranging in size from 2 to 8 micrometers. Bacteria are thought to have first evolved over 3 billion years ago. Bacteria cells lack membrane-bound organelles such as mitochondria, and have double-stranded circular DNA located in a region known as the nucleoid.

Bacteria have a phospholipid bilayer plasma membrane and an outer peptidoglycan cell wall which are together known as the cellular envelope.

The cell wall provides rigidity and stabilizes cell structure.

Bacteria replicate asexually through binary fission a process which involves growing in size, duplicating its genetic material and then splitting into 2 identical cells. Bacteria do have ribosomes which enable protein translation. Some bacteria have additional structures such as:
- plasmids = small linear or circular extra-chomosomal DNA, located outside of the nucleoid, that sometimes contain antibiotic resistant genes
- nutrient storage granules of carbon, or sulfur
- nutrient storage vacuoles of nitrogen
- an outer phospholipid bilayer membrane
- a glycocalyx which can form a capsule or a slime layer that can enable adhesion, as well as prevent dehydration, and prevent being phagocytosed.
- fimbriae for attachment
- pili to enable the transfer of plasmids from one bacteria to another, a process called bacterial conjugation
- flagella to enable movement
- gas vacuoles to provide buoyancy
- magnetosomes to enable directional movement
- endospore formation abilities – the ability to create a coating structure that can form surrounding the bacterial DNA and ribosomes and enable the bacteria to enter a period of dormancy in order to survive inhospitable environments for long periods of times. Endospores are resistant to dehydration, pH changes, extreme temperatures, and disinfecting agents such as chemicals or UV treatments.

Bacteria Morphology: Sizes, Shapes and Growth Patterns
Bacteria are always unicellular and come in many shapes and sizes (Fig. 1a). Rod-shaped bacteria are called bacilli. Spherical-shaped bacteria are called cocci, and spiral-shaped bacteria are called spirillum. Bacteria can also have fusiform-shapes, comma-shapes, club-shapes, corkscrew-shapes, filamentous-shapes or thin spirals (spirochetes), Depending on the species, bacteria can also grow individually or in clusters (e.g. staphylo-), or in chains (e.g. strepto-), or in groups of two (diplo-) or four (tetrads) or eight (sarcina), or in fence-like structures (palisades) and are given prefixes or descriptive terms to illustrate these preferences. Size, shape, and growth patterns can be used to help identify bacteria under the microscope.

Other strategies for helping to identify bacteria include use of different stains as well as culture testing.
Microscope Stains – Light Microscope Specimen Preparations
It is useful to be able to correctly characterize and identify different species of bacteria for research purposes as well as in diagnosing infectious diseases. Many different stains have been developed that highlight unique features or structures of various bacterial species (e.g. presence of endospores, flagella, capsules and cell wall components).
Gram Staining
Gram Staining is a procedure, developed by Hans Christian Gram, that involves several steps and is used to distinguish between bacteria based on the composition of their cell walls. During the procedure the cells are first stained with a Crystal Violet dye which is trapped and retained in the thick peptidoglycan cell walls that are present in some bacteria. These bacteria will appear purple under the microscope and are called Gram-positive cells. Cells that do not have a thick peptidoglycan cells will not retain the Crystal Violet dye and are called Gram-negative cells.

It is worth noting that the Gram-negative cells will not be clear under the microscope. This is because during the staining procedure, after the Crystal Violet application and washing step, a final step of applying a Safranin dye is involved, which stains the Gram-negative cells a pink colour. Therefore after Gram-staining, Gram-negative cells will appear pink and Gram-positive cells will appear purple.
Culture Testing
It is important to know which antibiotics will be most effective at treating a bacterial infection. As such a sample of the infecting specimen is collected from the host’s infected area by use of a swab (e.g. throat swab in a upper respiratory tract infection), or perhaps through collection of sputum, urine, feces, blood, or cerebrospinal fluid (CSF) to assess suspected bacterial infections of the lungs, urinary tract, GI tract, or nervous system.
The specimen is transferred to media that facilitates bacterial growth (e.g. nutrient-rich agar) . There are several types of tests that can then be done to help determine which species and strain of bacteria has been collected. These culture tests are often conducted in medical labs and include:
- assessing nutrient requirements using different growth medias,
- analyzing appearance of plated colonies,
- viewing bacteria under the microscope (with and/or without staining), and
- catalase tests,
- coagulase tests,
- oxidase tests,
- Sulfide Indole Motility (SIM) Medium tests,
- PCR testing is sometimes available which can be used to most accurately identify specific bacterial strains of each species.
(b) An inoculation loop like this one can be used to streak bacteria on agar in a Petri dish. (credit a: modification of work by Centers for Disease Control and Prevention; credit b: modification of work by Jeffrey M. Vinocur) (OpenStax Microbiology, Rice University).
The details of these tests will be briefly described in later sections. Most importantly culture testing is performed and the pathogenic bacteria species and strain is identified.
The next step is determining which antibiotic treatment will be most effective in treating the bacterial infection. This step is called Sensitivity Testing.
Sensitivity Testing
In this test, the pathogenic bacteria is transferred to new media (e.g. agar plates). Each agar plate (or area within a plate) contains a certain antibiotic. If the bacteria does not grow in the presence of a specific antibiotic, we would say that this bacteria strain is sensitive to this antibiotic, and this antibiotic might be selected and used to successfully treat this bacterial infection. However, if the bacteria grows in the presence of a specific antibiotic on the plate, we would say that this bacteria is resistant to this antibiotic, and this antibiotic would not be effective at treating this type of bacterial infection.
